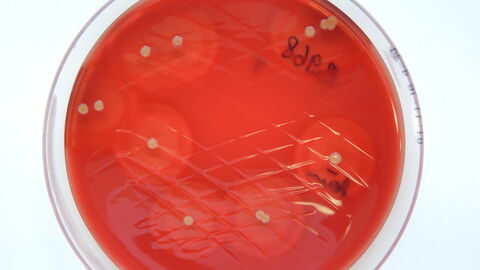
Staphylococcus aureus aus einer Tankmilchprobe auf Rinderblut-Äskulin-Agar
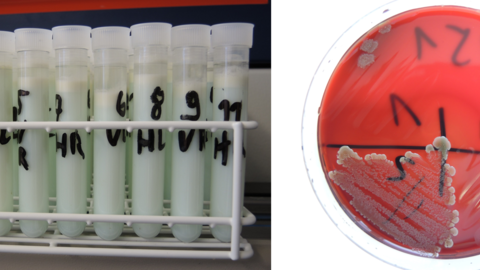
Milchprobenröhrchen nach Registrierung im Labor und kulturelles Wachstum von Mastitiserregern nach Inkubation im Brutschrank
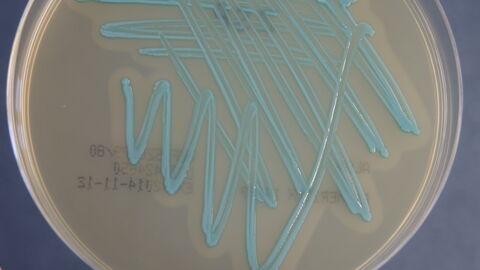
Nachweis von Listeria monocytogenes aus Tankmilchprobe (Aloa-Spezialagar)
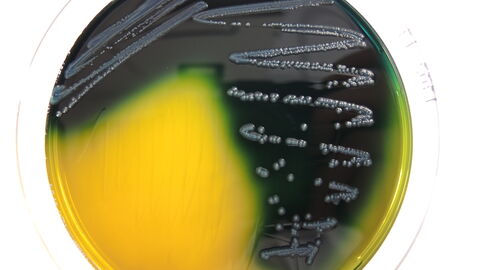
Abb. 9: Escherichia coli auf Gassner-Agar
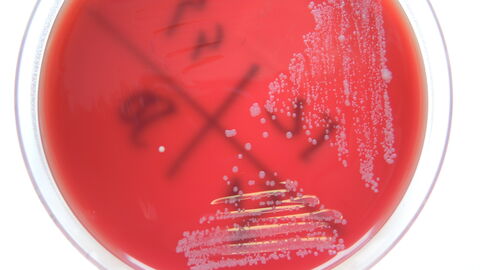
Prototheken auf Rinderblut-Äskulin-Agar

Wurde von hessischen Milchviehhaltern beim Vorliegen eines Eutergesundheitsproblems ein Antrag zur Inanspruchnahme des Eutergesundheitsdienstes durch den Hof- oder Milchhygienetierarzt bei der Hessischen Tierseuchenkasse (HTSK) gestellt, dann werden nach Bewilligung durch die HTSK sogar vier Fünftel der Untersuchungskosten übernommen. Ein bewilligter EGD-Antrag ist für jeweils ein Kalenderjahr gültig.
Sollte ein Betrieb vermehrt Probleme mit subklinischen Euterentzündungen haben, so besteht die Möglichkeit, in speziellen Probenröhrchen mit Schraubdeckel die Milch zunächst einzufrieren und zu sammeln. Wenn dann von einigen Tieren Milchproben vorliegen, können diese in einer Einsendung verschickt werden und die Untersuchung beginnt.
Der Milchbefund
Bei der Auswertung des Milchbefunds muss man zunächst darauf achten, welche Leitkeime nachgewiesen wurden. Sind es eher euterassoziierte Mastitiserreger oder sogenannte Umweltkeime (s. Abb. 8). Gerne stehen wir für eine telefonische Beratung des Milchbefunds der in unserem Labor untersuchten Proben zur Verfügung.
Bei der Coli-Mastitis, verursacht durch das Bakterium Escherichia coli, (Abb. 9) können Toxine im Spiel sein und es muss, ebenso wie beim Erreger der Holsteinischen Euterseuche (Trueperella pyogenes) besonders schnell gehandelt werden, um das Euterviertel oder gar das gesamte Tier retten zu können. In diesen Fällen erstellen wir auch Vorabbefunde, um schnellstmöglich die Information weiter geben zu können.